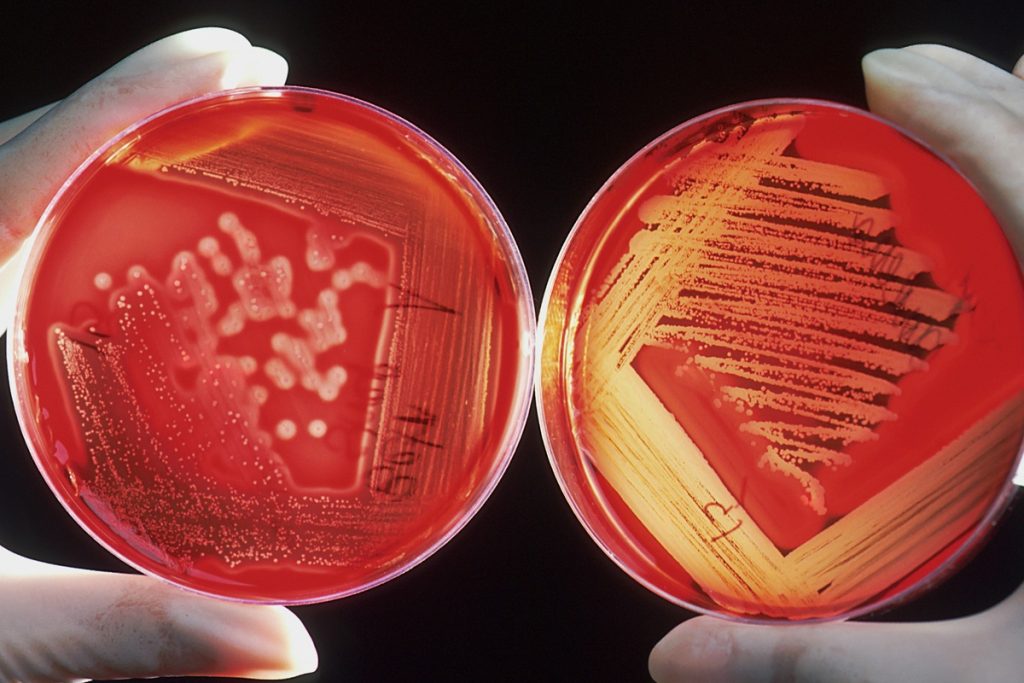
branduri 1

Știință, calitate, încredere. Din 1992. Kastel Daro Tim - furnizorul care a trecut testul timpului.
Cine este Kastel Daro Tim?
Kastel Daro Tim SRL este probabil primul distribuitor în acest domeniu de pe piata timisoreană. Oferim reactivi chimici, sticlărie și echipamente de laborator dedicate cercetării, industriei și instituțiilor de învățământ. Oferim produse de calitate și soluții fiabile pentru laboratoare moderne, punând accent pe profesionalism, promptitudine și parteneriate de încredere.
Prin portofoliul nostru de reactivi chimici, sticlărie și echipamente de laborator, susținem activitatea laboratoarelor din domeniul cercetării, educației și industriei. Ne concentrăm pe furnizarea de produse fiabile și pe construirea unor relații durabile cu partenerii noștri.

